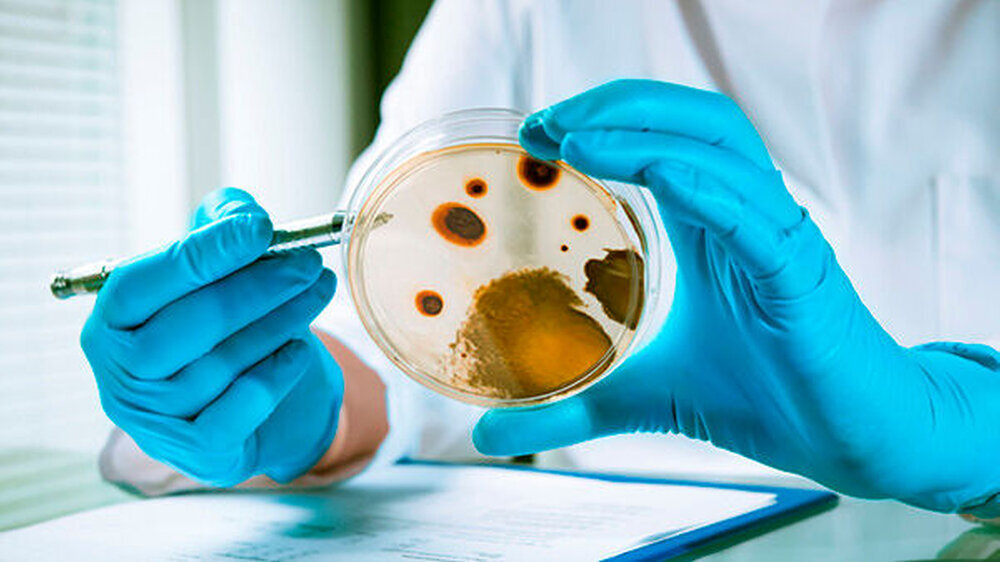

Bakterien: die Mini-Siegfrieds
Über Nacht wuchern sie heran und sorgen morgens für ein stumpfes Gefühl auf den Zähnen: Bakterienteppiche. Auch beim Hausputz begegnen wir ihnen regelmäßig: die schleimige Schicht im Abfluss, der glibberige Streifen am Spülmaschinenrand - alles Bakterien. Überall, wo es feucht ist, vermehren sie sich rasend schnell. Und bilden organisierte Lebensgemeinschaften, um sich zu schützen.
Nahezu unbesiegbare Heerschaften
Das gelingt ihnen hervorragend. Denn Biofilme sind fast unbesiegbar: Weder Desinfektionsmittel, noch Antibiotika noch unser eigenes Immunsystem kommen ihnen bei. In Schach halten kann man sie am besten mechanisch: durch beständiges Schrubben und Schaben.
Was im Haushalt und bei der Mundhygiene hilft, ist anderswo aber unmöglich: Biofilme befallen Hüftprothesen und Herzklappen, verstopfen Gallenstents und Blasenkatheter. Wissenschaftler schätzen, dass sie für mindestens zwei Drittel aller Infektionen verantwortlich sind, wodurch sie Kosten in Milliardenhöhe verursachen.
Die Bewohner der Keim-WG verstehen
Kein Wunder, dass Forscher weltweit nach Möglichkeiten suchen, Biofilme zu kontrollieren. Der Mikrobiologe Wolf-Rainer Abraham vom Helmholtz-Institut für Infektionsforschung in Braunschweig, möchte das „Gute“ in ihnen fördern: „Eliminieren kann man sie nicht. Also müssen wir versuchen, aus gefährlichen Biofilmen ungefährliche zu machen. Dazu müssen wir die Gemeinschaften so gut verstehen, dass wir verhindern, dass pathogene Keime einwandern.“
###more### ###title### Wettrennen nach der Zahn-OP ###title### ###more###
Wettrennen nach der Zahn-OP
Konkret geht es dabei um Zahnimplantate. Zwar werden Patienten schon vor dem Eingriff vorsorglich mit Antibiotika behandelt, dennoch entwickeln sich oft Infektionen (je nach Implantat 3 bis 40 Prozent). „Nach der Operation kommt es dann zu einer Art Wettrennen: Wer besiedelt die neue Oberfläche zuerst? Bakterien oder die Zellen des Patienten?“, sagt Abraham. Der Forscher möchte Biofilme über die Beschaffenheit der Oberfläche kontrollieren. Die Idee ist, dass es Oberflächen geben muss, die auf Bakterien abstoßend wirken.
Dazu testen Abraham und seine Kollegen verschieden gestaltete Oberflächen, indem sie Biofilmproben aus der Zahnklinik oder aber auch den eigenen Zahnbelag hinzufügen. Sind die Bakterien dort angewachsen, werden sie genetisch identifiziert und die Architektur ihrer Kolonien unter dem Mikroskop begutachtet. „Von manchen Oberflächen verschwinden manche Arten. Oder sie sind dort plötzlich prominent. Auf manchen Oberflächen bekommen die Bakterienteppiche Risse.
Schleim wie Drachenblut
"So tasten wir uns langsam vor"“, sagt Abraham. Was Bakteriengemeinschaften so unbesiegbar macht, ist ihr Schutzwall. Die sogenannte extrazelluläre Matrix besteht aus einer Art Schleim, einem hochkomplexen Gemisch aus Zucker, Proteinen und anderen Molekülen, das die Bakterien selbst produzieren.
Die Schleimhülle hält Wasser zurück, so dass ihre Bewohner nicht austrocknen. Außerdem verhindert sie, dass Antibiotika oder Immunzellen wie Antikörper und Fresszellen zu ihnen vordringen. Sie dient auch als eine Art Außenmagen, in dem sie verhindert, dass Enzyme weggespült werden, die Partikel zersetzen. Diese Funktion etwa macht Biofilme in der Abwasserreinigung unersetzlich, so erklärt es der Wissenschaftler.
###more### ###title### "Gute" Biofilme ###title### ###more###
"Gute" Biofilme
Denn nicht alle Biofilme sind Feinde. In der Natur sind Bakterienverbände an allen Stoffkreisläufen beteiligt, also am Um- und Abbau organischen und anorganischen Materials. Und die Lebensgemeinschaften auf unserer Haut, insbesondere unseren Schleimhäuten, schützen uns vor krankheitsverursachenden Keimen. Auch unsere Darmflora hat diese Funktion. Das Gleichgewicht ist allerdings labil und normalerweise unschädliche Bakterien können sich plötzlich zu unangenehmen Mitbewohnern entwickeln.
Aber Bakterien produzieren ihre schützende Schleimhülle nicht sofort. Zunächst müssen sie sich auf einer Oberfläche niederlassen, also fest anheften. Das gelingt ihnen durch „Adhäsine“, speziellen „Landesensoren“. Der Mikrobiologe Friedrich Götz von der Universität Tübingen konzentriert sich bei seiner Forschung auf diesen ersten Schritt der Biofilmbildung: „Adhäsine können sich an fast alles anheften. Auch an nicht-organischen Materialien, an Metallen fast so gut wie an Kunststoffen wie Silikon und Polycarbonaten“, sagt Götz.
Oberfläche ohne Landeplatz
Seine Arbeitsgruppe hat bereits zahlreiche Adhäsine identifiziert und einige Wirkstoffe gefunden, die sie hemmen. Momentan favorisiert Götz einen Ansatz, den er und seine Kollegen nur über einen Umweg entdeckten: Sie entwickelten eine beschichtete Oberfläche von der fädige Strukturen abstehen, einem Tierpelz nicht unähnlich. Erste Versuche mit Bakterien sahen vielversprechend aus: Die Mikroorganismen hatten Schwierigkeiten anzudocken.
###more### ###title### Blut wirkt wie Klebstoff ###title### ###more###
Blut wirkt wie Klebstoff
Bedeckten die Forscher die pelzartige Oberfläche aber mit Blut, um die natürliche Umgebung im Körper nachzustellen, wuchs wieder ein Bakterienteppich heran. Die Forscher fanden heraus, dass Blutbestandteile wie Immunglobuline an die Oberfläche binden und Bakterien wiederum als „Anker“ dienen.
"Wie wir zeigen konnten, waren Immunglobuline die wichtigsten Rezeptoren für die Bakterien. Daraufhin haben wir die Bakterien vorab mit Immunglobulinen behandelt und konnten so eine drastische Verringerung der Adhäsion erzielen", sagt Götz. Die „Landesensoren“ der Bakterien sind dann vollständig mit Immunglobulinen blockiert, so dass sie nirgendwo mehr „kleben“ bleiben. „Das könnte in eine neue Strategie münden, die Biofilmbildung von Beginn an zu hemmen“, so Götz.
Wie Bakterien ein Haus bauen
Haben sich Bakterien erst einmal niedergelassen, vermehren sie sich zügig - und fangen an, sich „abzusprechen“. Ähnlich Schiffsbrüchigen, die Leuchtraketen abschießen, geben Bakterien fortwährend Signalmoleküle in ihre Umgebung ab. Wächst eine Bakterienpopulation, nimmt die Konzentration dieser Signalmoleküle zu.
Wird ein bestimmter Schwellenwert überschritten, verändert die Bakteriengemeinschaft schlagartig ihr „Verhalten“: Bestimmte Gene werden aus-, andere eingeschaltet. Das bedeutsamste Gemeinschaftswerk: der Aufbau der Schleimhülle. Die Fähigkeit der Bakterien, ihre Dichte über eine Art chemische Sprache zu messen, bezeichnen Forscher als Quorum Sensing (QS).
Es ist ungeheuer faszinierend, dass derart einfache, einzellige Organismen fähig sind, auf diese Weise zu kommunizieren“, sagt der Mikrobiologe Leo Eberl von der Universität Zürich. Seine Arbeitsgruppe hat mehrere Gene identifiziert, die über QS reguliert werden und an der Biofilmbildung beteiligt sind. Ziel der QS-Forschung ist die Suche nach Wirkstoffen, die die Kommunikation zwischen Bakterien und damit ihr Teamwork unterbrechen.
Ein Beispiel für ein solches Molekül ist Ajoen, das aus Knoblauch isoliert wurde. Auch in anderen Heilpflanzen und Gewürzen wurden QS-hemmende Substanzen entdeckt. „Keime, die Pflanzen befallen, koordinieren ihren Angriff ebenfalls per QS. Deswegen liegt die Annahme nahe, dass Pflanzen über entsprechende Abwehrmechanismen verfügen“, so Eberl.
Nicht gemacht fürs Single-Dasein
Einen Vorteil haben alle neuen Ansätze im Vergleich zu herkömmlichen Antibiotika: Da sie nicht direkt in das Wachstum der Bakterien eingreifen, ist die Wahrscheinlichkeit, dass Bakterien Resistenzen entwickeln, geringer. Allerdings haben alle neuen Ansätze auch einen entscheidenden Nachteil: Bisher hemmen sie allenfalls die Biofilmbildung und verhindern sie nicht vollständig.
"Wir haben ja lange Zeit angenommen, dass Bakterien als Singles leben. Heute wissen wir, dass sie überwiegend in Gemeinschaften organisiert sind", sagt Eberl, „dazu kommt, dass sie über drei Milliarden Jahre Zeit hatten, die besten Überlebensstrategien zu entwickeln - wir haben noch reichlich zu lernen.“
Quellen: Abraham, Wolf-Rainer Wolf-Rainer.Abraham@helmholtz-hzi.deFriedrich Götz, friedrich.goetz@uni-tuebingen.deLeo Eberl leberl@botinst.uzh.ch